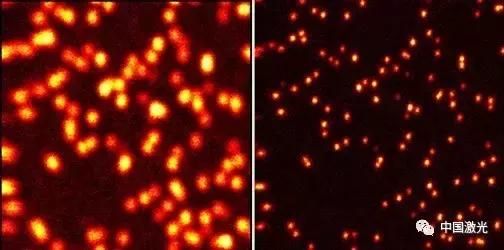
光学学报,光学学报什么水平

1、雷铭:中科院西安 光机所研究员

2、孙育杰:北京大学 生命科学学院研究员

3、李辉:中科院苏州生物医学工程技术研究所研究员
众所周知, 光学成像技术 具有成像速度快、可实现无损观察等优点,在人类探索和发现未知世界奥秘的活动中一直扮演着重要的角色。随着现代科学的发展,对微观结构的研究迫切希望能够从分子水平揭示生命过程和材料性能的物理本质。
受限于光的衍射特性,光学成像系统的空间分辨率不可能无限小,存在瑞利-阿贝物理极限。传统光学显微镜的空间分辨率最高只能达到波长的1/2,故而对低于200 nm的细节信息无能为力。能否突破这个极限成为当今光学领域公认的一个重大研究课题和挑战。
超分辨成像技术是近些年来发展最快、受关注度最高的光学成像技术之一。这类技术突破了光学衍射极限,将光学显微镜的分辨率从几百纳米提高到了几纳米,已逐渐成为学者们研究微观结构和过程的一种强有力的工具。
超分辨显微成像系统对荧光小球的成像结果图
左图:共聚焦显微镜成像,分辨率200nm;右图:STED超分辨显微成像结果,分辨率50nm。
(图片来源于中科院苏州生物医学工程技术研究所网站)
目前主流的超分辨光学成像技术主要分为两大类:一类是基于单分子定位技术的超分辨显微成像方法,包括光激活定位显微技术(PALM)和随机光学重构显微技术(STORM);另一类是基于点扩展函数调制的超分辨显微成像方法,包括受激发射损耗显微技术(STED)和结构照明显微技术(SIM)。
另外,飞速发展的计算机深度学习技术、图像处理算法以及新型荧光探针的发现有可能为超分辨成像技术带来新的突破。2014年诺贝尔化学奖分别授予Eric Betzig,Stefan W. Hell和William E. Moerner三位科学家,以表彰他们在超分辨荧光显微成像技术方面的重大贡献。
近年来,超分辨光学成像技术的相关研究受到了国内众多研究团队以及交叉学科领域学者的关注,涌现出大量高水平的研究工作。为了方便广大读者了解、讨论和交流国内在超分辨光学成像技术及应用领域的发展,《光学学报》精心组织了“超分辨成像”专题(2017年第3期),涵盖了多位相关领域专家和团队近年来的代表性研究成果。优选的十余篇相关方向的最新研究论文和综述,主要内容包括超分辨光学成像的新原理和新技术、超分辨光学图像重构算法、新型荧光探针以及超分辨光学成像技术在生物医学中的应用等。
专题特邀文章:
1、结构光照明显微中的超分辨图像重建研究
作者:周兴 但旦 千佳 姚保利 雷铭
2、结构导向的可逆光激活绿色荧光蛋白探针的研制
作者:王盛 陈轩泽 常蕾 薛瑞莹 孙育杰
3、基于激光干涉的结构光照明超分辨荧光显微镜系统
作者:文刚 李思黾 杨西斌 王林波 梁永 金鑫 朱茜 李辉
4、超分辨定位成像中的像差表征和校正
作者:赵泽宇 张肇宁 黄振立
5、随机光学重构显微成像技术及其应用
作者:杨洁 田翠萍 钟桂生
6、自外而内的单幅图像超分辨率复原算法
作者:郑向涛 袁媛 卢孝强
7、光片荧光显微成像
作者:杨豫龙 宗伟建 吴润龙 陈良怡
8、荧光蛋白与超分辨显微成像
作者:彭鼎铭 付志飞 徐平勇
中国激光 微信公众号整理
如需转载,请关注本公众号
发送需求得到同意后转载,并注明出处
投稿邮箱:mail@opticsjournal.net